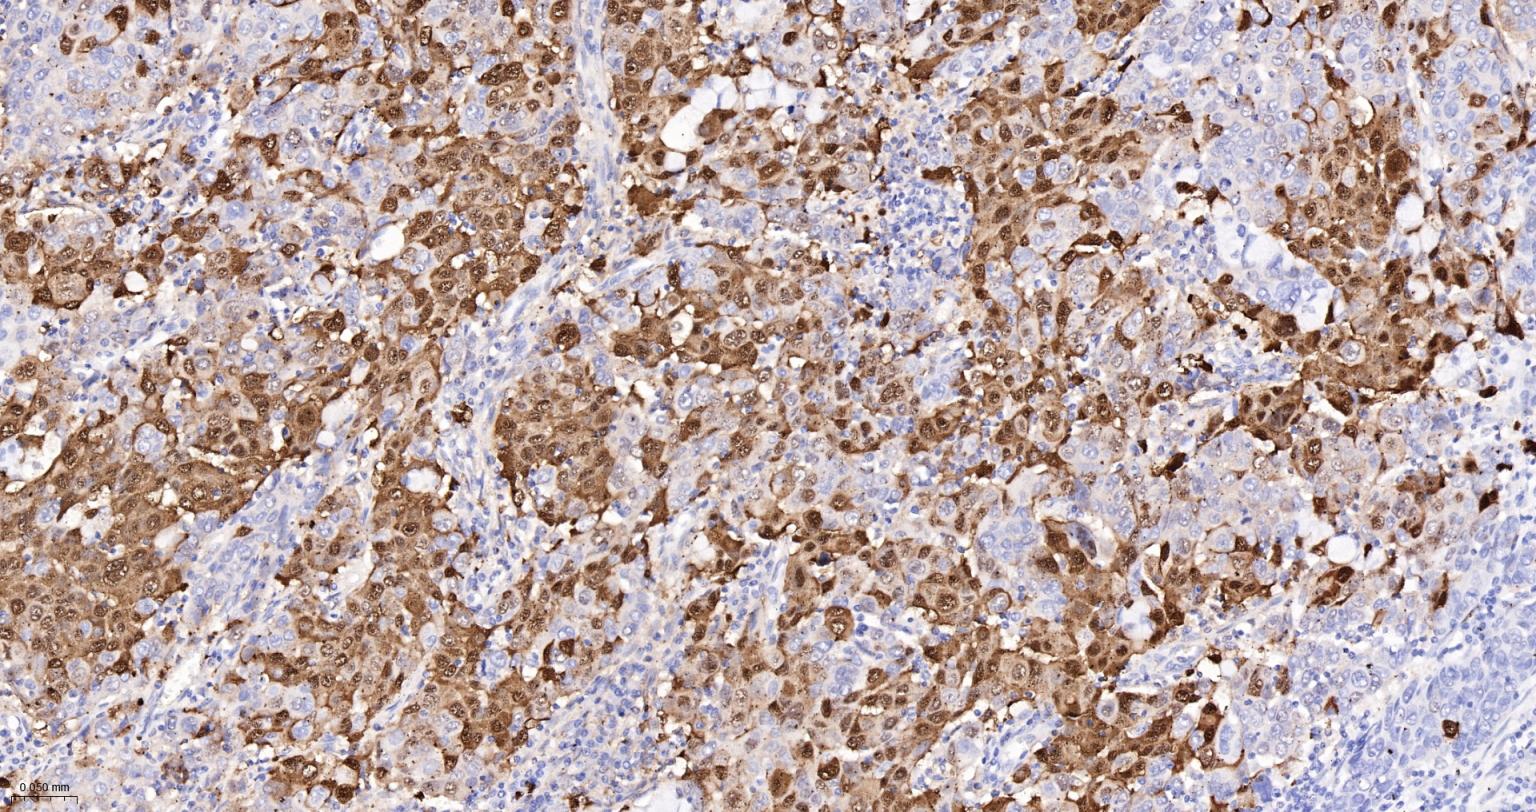
缺氧诱导因子1α /HIF-1α重组兔单抗-bsm-62518R

Cancer > Invasion/microenvironment > Hypoxia > HIF
Cancer > Invasion/microenvironment > Hypoxia > Hydroxylases
Epigenetics and Nuclear Signaling > Cardiovascular/Immune > Hypoxia > HIF
Epigenetics and Nuclear Signaling > Chromatin Modifying Enzymes > Jumonji containing proteins
Epigenetics and Nuclear Signaling > Chromatin Modifying Enzymes > Methylation
Functions as a master transcriptional regulator of the adaptive response to hypoxia.Under hypoxic conditions, activates the transcription of over 40 genes, including erythropoietin, glucose transporters, glycolytic enzymes, vascular endothelial growth factor, HILPDA, and other genes whose protein products increase oxygen delivery or facilitate metabolic adaptation to hypoxia.

| 应用 | 已检合格种属 | 预测种属 | 推荐稀释比例 |
|---|---|---|---|
| WB | Human | 1:500-2000 | |
| IHC-P | Human | 1:100-500 | |
| IHC-F | Human | 1:100-500 | |
| IF | Human | 1:100-500 | |
| Flow-Cyt | Human | 1:50-100 | |
| ICC/IF | Human | 1:50-200 |
交叉反应: Human
暂无相关产品